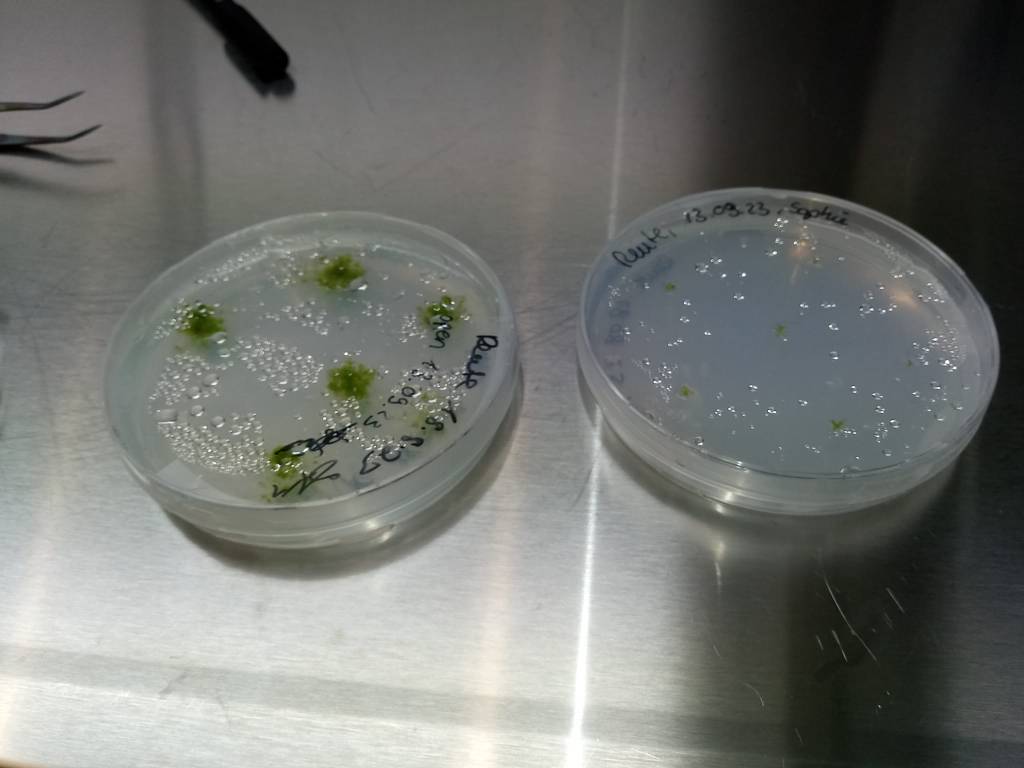

Check out the preview to our latest JoVE paper:
Rup (RNA-seq Usability Assessment Pipeline) – Quality Control for Bulk RNA-seq Experiments in Eukaryotes.
Here you’ll find the full video -> https://hubs.ly/Q03ZfCMC0.
This month and next month, our six ICIPS members (5 PhD-students & 1 Postdoc) are going to take part to the forth “Soft Skills” workshop about “How to be more employable in private sector” organized by ICIPS and provided by Dr. David Glitner of the NaturalScience.Careers company.
Thank you to both of him for this very interesting and usefull workshop.
Last week, all ICIPS members met in Gießen for our fourth annual “Report & Retreat” Meeting!
We had intensive discussions and workshops during 3 days … and, of course, some well-deserved relaxing time on the Lahn river.



Actualia – DBG Newsletters
A conference report about our Berlin Symposium has been published in the DBG Newsletters “Actualia“ (the German Society of Plant Sciences).
You can read it here:

ICIPS on TV 🎥🌱
The German national radio/TV channel NDR presented on 18.5.2025 (at 7.30 pm) some ICIPS works done within the group of Prof. Sabine Zachgo in Osnabrück during a short documentary entitled:
“Brunnenlebermoos – der unscheinbare Star in der Forschung”
(“Fountain Liverwort (Marchantia) – the discrete Star in research” in English)
You can watch it here:
https://www.ndr.de/fernsehen/sendungen/hallo_niedersachsen/Brunnenlebermoos-der-unscheinbare-Star-in-der-Forschung,hallonds95228.html

101 scientists (39 PIs, 22 Postdocs, 35 PhD-students and 5 sponsors) from eleven different countries (China, Czech Republic, France, Germany, Irland, Israel, Italy, Japan, Switzerland, UK & USA) participated to the international “ICIPS” Symposium “Evolution of Plant Reproduction” from Tuesday 25th till Friday 28th of March in Berlin (Germany).

Melanie Trupp (Osnabrück University) won the best PhD Talk prize for her oral presentation entitled “Contribution of the TGA TF to the evolution of sexual reproduction” given during session 7: Co-Evolution of Signaling Systems and Gene Regulatory Networks in Plant Development (with a score of 57.5/60 points). She competed with 10 other PhD students presenting their doctoral results during the ICIPS symposium.

Ms. Caterina Baldi (Sponsor: Novogene Europe – right picture) & Prof. Annette Becker (JLU University Gießen) awarded the diploma for the best poster to the two winners (they obtained the same number of votes):
– Camille Salaün (Max Planck Institute – Potsdam – left picture): “Genetic determinants of autonomous endosperm formation in Arabidopsis” (Poster n° 4 – right poster on screen),
– Nicholas Desnoyer (University of Zürich – central picture): “Open Flower: A blooming model for teaching, outreach and research” (Poster n° 2- left poster on screen ).



Thanks to all our sponsors (DFG German Research Foundation, DBG German Society for Plant Sciences, The Company of Biologists, Novogene & CLF PlantClimatics), we were able to attribute international and national travel grants to six early-career researchers (5 PhD students and 1 early postdoctoral researcher) to help them to travel to Berlin (Germany) and participate to the ICIPS symposium:
– Bridget Bickner (Harvard University – USA – top left picture) presented a flash talk/poster entitled “Evolution and development of ovule packaging variation in the Phlox genus” (Flash Talk & Poster n° 3).
– Yukiho Toyama (University of Tokyo – Japan – top center picture) was selected to present an oral presentation entitled “Tissue-specific transcriptome analysis and chemotactic behavior observation reveal the intermediate evolutional state in male reproductive cells of Gymnopserm Cycads” (Session 5).
– Pavla Novotná (Institute of Biophysics of the Czech Academy of Sciences in Brno – Czech Republic – top right picture) presented a poster entitled “How to elucidate dosage compensation and parental conflict in Silene latifolia” (Poster n°12)
– Nicola Babolin (University of Milano – Italy – bottom left picture) was selected to present an oral presentation entitled “Maternal regulation of nutrients availability plays a pivotal role during ovule and seed development” (Session 6).
– Dr. Emanuela Talarico (University of Calabria- Italy – bottom center picture) was selected to present an oral presentation entitled “Pollen-Mediated Control of Ovule Development in Ginkgo biloba: Insights into Auxin Regulation and Epigenetic Mechanisms” (Session 6).
– Siwei Pang (JLU University Gießen – Germany – bottom right picture) presented a poster entitled “The role of JAGGED-like zinc finger transcription factors in the alternation of generations and the origin of multicellular sporophyte” (Poster n°17)






During the international “ICIPS” Symposium “Evolution of Plant Reproduction“, 46 speakers presented their results in eight different sessions:
Session 1 about Innovation of Pollen and their Reception/Rejection Systems on Tuesday (25.03) afternoon (Chair: Thomas Dresselhaus):
Self-incompatibility: diverse mechanisms involved in allorecognition and prevention of self-fertilization
by Noni Franklin-Tong (University of Birmingham)
Transcriptional regulation of dominance at the self-incompatibility locus in Arabidopsis
by Matteo Barois (University of Lille) ·
Unravelling pollen-ovule cross-talk in Ginkgo biloba: insights into gymnosperm reproductive biology
by Silvia Moschin (University of Padova)
Functional analysis of RALF gene family members in maize and their evolution
by Xia Chen (University of Regensburg)
Molecular evolution of epigenetically regulated pollen genes
by Daniel Bouyer (CNRS – Lyon)
Evolving as a couple: diversification of the ligand-receptor interaction for self-incompatibility
by Marie Monniaux (University of Lille)








Session 2 about Evolution of Multicellular Embryos and Endosperm on Wednesday (26.03) morning (Chair: Duarte Figueiredo):
Embryo-endosperm communication in developing seeds: Establishing the boundaries of an ambiguous relationship
by Gwyneth Ingram (ENS – Lyon)
Paternally derived brassinosteroid effectors as regulators of ab initio cellular endosperm formation
by Rency Tomy Pulickal (MPI – Potsdam)
Unravelling the molecular basis of endosperm evolution
by Daniela Barro-Trastoy (MPI – Postdam)
MAP kinase signaling in cell polarity – how parental signals shape the plant embryo
by Martin Bayer (University of Tübingen)
The origin and evolution of apomixis-associated chromosomes in Boechera
by Terezie Mandakova (Masaryk University)
Transposon-driven endosperm evolution and its consequences for angiosperm diversity
by Claudia Köhler (MPI – Postdam)













Session 3 about Evolution of Ovules and Seeds on Wednesday (26.03) midday (Chair: Günter Theißen):
Angiosperm seeds are a mess!
by William Friedman (Harvard University)
SPOROCYTELESS and MADS-domain factors are required for differentiation of megaspore mother cell
by Lucia Colombo (University of Milan)
SEPALLATA driven MADS complex formation is required for ovule and seed development in Arabidopsis
by Véronique Hugouvieux (CNRS/CEA/UGA – Grenoble)
Deciphering the diversity of the 3D cellular basis of ovule curvature
by Kay Schneitz (Technical University of Munich)
Tools for genetic studies of the model fern Ceratopteris richardii
by Robin Schulz (University of Jena)
Finding the ‘seed’ in seedless plants
by Andrew Plackett (University of Birmingham)












Session 4 about Evolution of Carpels and Fruits on Wednesday (26.03) afternoon (Chair: Annette Becker):
Development sculpting floral sexuality and floral fertility in the grasses
by Madelaine Bartlett (Cambridge University)
The problem of carpel identity and gynoecium diversity in grasses (Poaceae)
by Dmitry Sokoloff (Tel Aviv University)
The role of LEUNIG and SEUSS transcriptional regulators during land plant evolution
by Julian Garrecht (University of Giessen)
Characterisation of MADS transcription factors complexes in Gymnosperms and the origin of the flower
by Aline Janeau (Grenoble Alpes University)
How to grow apart: the evolution of sex determination in Cannabis sativa
by Rainer Melzer (University College Dublin)
The mechanism and evolution of ovule curvature and its importance to hypotheses for the origin of angiosperms by Charlie Scutt (ENS – Lyon)











Session 5 about Evolution of Fertilization Mechanisms in Plants on Thursday (27.03) morning (Chair: Stefanie Sprunck):
Evolutionary insights into double fertilization
by Tetsuya Higashiyama (University of Tokyo)
Evolution and function of EC1 and other ECA1 gametogenesis-related small secreted cysteine-rich proteins
by Sophie Tiedemann (University of Regensburg)
Science to soil: unlocking three-parent breeding for sustainable agriculture
by Saurabh Joshi (University of Bremen)
Tissue-specific transcriptome analysis and chemotactic behavior observation reveal the intermediate evolutional state in male reproductive cells of Gymnosperm cycad
by Yukiho Toyama (University of Tokyo)
Accessing the inaccessible: microinjection in Arabidopsis thaliana reproductive cells
by Joakim Palovaara (University of Bremen)
The evolution and roles of endopeptidases in plant fertilization
by Meng-xiang Sun (Wuhan University)












Session 6 about From ROS to hormones: Regulatory processes shaping land plant growth and fertility
on Thursday (27.03) midday (Chair: Stefanie Müller-Schüssele):
Phenolic oxidative polymerization as an unexplored facet of cuticle formation
by Hugues Renault (University of Strasbourg)
Interplay of the TGA transcription factor MpTGA and its glutaredoxin co-regulators the ROXYs in Marchantia polymorpha sexual reproduction
by Nora Gutsche (Osnabrück University)
Conservation of sporophyte secondary cell wall development and pectin biosynthesis in land plants
by Class II KNOX
by Tom Dierschke (University of Zürich)
Maternal regulation of nutrients availability plays a pivotal role during ovule and seed development
by Nicola Babolin (University of Milan)
Pollen-mediated control of ovule development in Ginkgo biloba: insights into auxin regulation and
epigenetic mechanisms
by Emanuela Talarico (University of Calabria)
Evolution of receptor kinases signaling in land plants: from immunity to reproduction
by Isabel Monte (University of Tübingen)











Session 7 about Co-Evolution of Signaling Systems and Gene Regulatory Networks in Plant Development on Friday (28.03) morning (Chair: Sabine Zachgo):
Reproductive strategy control in Marchantia polymorpha
by Sebastian Schornack (University of Cambridge)
Contribution of the TGA TF to the evolution of sexual reproduction
by Melanie Trupp (Osnabrück University)Conservation and divergence of the FERONIA signal transduction pathway in Marchantia polymorpha (replaced at the last minute by Nicholas Desnoyer (University of Zürich))
by Ueli Grossniklaus
Arrested development: How do plants control the timing of identity transitions in embryonic stomatal cells?
by Margot Smith (University of Tübingen)
Mechanical control of germ cell specification in Arabidopsis anthers
by Feng Zhao (Northwestern Polytechnical University)
Unraveling epidermal cell differentiation in Arabidopsis flowers
by Kerstin Kaufmann (Humboldt University of Berlin)









Session 8 about Bioinformatics solutions to harness the EvoDevo data universe chaos on Friday (28.03) midday (Chair: Alexander Goesmann):
Cross-plant comparison of gene expression
by Oliver Rupp (University of Giessen)
California poppy (Eschscholzia californica) genome and transcriptome atlas shed light on the concerted evolution of complete metabolic pathways
by Clemens Rössner (University of Giessen)
Open Flower: a blooming model for teaching, outreach and research
by Nicholas Desnoyer (University of Zürich)
Genomic imprinting and regulatory networks in seed initiation of an early-diverging Angiosperms
by Ana Marcela Florez-Rueda (MPI – Postdam)
Genomic and phenotypic coevolution in land plants
by James Clark (University of Bath)





Before the end of the second day, a “Flash Talk” session (5min. / 3 slides per speaker) was organized to allow certain researchers to present and advertise their poster:
– Role of DNA methylation in asexual endosperm formation (Poster n°1) by Dilsher Singh Kulaar
– Duplication of MADS-box genes in land plants empowered the functional divergence between sporophytes, gametophytes and endosperm (Poster n°2) by Yichun Qiu
– Evolution and development of ovule packaging variation in the Phlox genus (Poster n°3) by Bridget Bickner
– Genetic determinants of autonomous endosperm formation in Arabidopsis (Poster n°4) by Camille Salaün
– Maternal control of RNA decay safeguards embryo development (Poster n°5) by Gerardo Del Toro-De León
– CoExPlore: Interactive comparative analysis of co-expression networks (Poster n°6) by Micha Frederick Keßler






Two Poster Sessions were organized at the end of the first and second days. These two sessions generated a lot of discussions between the participants of the ICIPS symposium. Twenty-four posters were presented and discussed (see list with title and authors here).









Since the 31st of October, the REGISTRATION WEBPAGE of
our international “ICIPS” Symposium “Evolution of Plant Reproduction”
is ONLINE!!
If you would like to participate to this interesting conference, which will take place in Berlin
between Tuesday 25th and Friday 28th of March,
please, register yourself
NOW !!
(and get the Early-Bird discount!)
Congratulations to Julian Garrecht, ICIPS PhD student in the group of Prof. Annette Becker, who has recently been awarded the Annette Kade Fellowship from the New York Botanical Garden.

He will be sponsored to work at this prestigious institution with Prof. Barbara Ambrose for three months next year (early 2025).
2025

2024
Last month, our ICIPS-colleagues from the University of Kaiserstlautern-Landau (RPTU; PhD student Julian Ingelfinger in the pictures) received a visit from a group of pupills in their “Moss”-lab (working group: Prof. Stefanie Müller-Schüssele).
Together they looked under the microscope at the different stages of sexual reproduction in the spreading earth moss, Physcomitrium patens. In this species, the sperm cell is mobile and uses its flagellated sperm cell (spermatozoid) to swim to the egg cell.


We are proud to announce that Clemens Rössner (PhD student) and his PhD-supervisor, Prof. Annette Becker from department of Botany of the University of Gießen as well as Sven Griep from the department of Bioinformatics published together an article entitled :“A land plant phylogenetic framework for GLABROUS INFLORESCENCE STEMS (GIS), SUPERMAN, JAGGED and allies plus their TOPLESS co-repressor” in the journal Molecular Phylogenetics and Evolution.
DOI: https://doi.org/10.1016/j.ympev.2024.108195.
Our ICIPS Blast Server is also published in this paper.
Congratulations to all the authors.
Last month, all ICIPS members met at the castle Rauischholzhausen for our third annual “Retreat” Meeting!
We had very productive and intensive discussions during these 3 days.
Thanks to our two external guests, Dr. Sophie de Vries (Univ. of Göttingen) and Dr. Andrew Plackett (Univ. of Birmingham) for their participation to this very productive meeting.
We are also proud to announce that the PhD-students, Julian Garrecht (JLU, Gießen) had the opportunity to give a talk about some of their LEUNIG & SEUSS PhD-results during the IBC2024 conference in Madrid (21-27/7). Congratulations to him!




We are proud to announce that two of our ICIPS PhD-students, Robin Schulz (Univ. of Jena) & Julian Ingelfinger (Univ. of Kaiserslautern), presented some of their PhD-results during the poster session of the IBC2024 conference in Madrid (21-27/7). Congratulations to both of them!


We are proud to announce that one of our ICIPS PhD-student, Sophie Tiedemann from the University of Regensburg presented some results of her PhD-project about evolution and function of EC1 proteins at the ICSPR 2024 conference while Prof. Annette Becker (JLU, Gießen) announced officially the DFG-ICIPS meeting “Evolution of plant sexual reproduction” taking place next year (when: 25-28 March, 2025, where: Berlin – Germany).


Last month, our six ICIPS members (5 PhD-students & 1 Postdoc) took part to the third “Soft Skills” workshop about “Oral & Poster presentations” organized by ICIPS and provided by Dr. Karin Bodewits and Dr. Philipp Gramlich of the NaturalScience.Careers company.
Thank you to both of them for this very interesting and usefull workshop.
Last month, our ICIPS member, Melanie Trupp from the University of Osnabrück visited the lab of Prof. Peter Szovenyi at the University of Zürich. During these days, she learned how to transform Anthoceros agrestis. Thank a lot to Prof. Szovenyi for hosting her and Manuel Waller for teaching her.



We are proud to announce that two of our ICIPS members Prof. Stefanie Sprunck and her PhD-student, Sophie Tiedemann from the University of Regensburg published an article “EGG CELL 1 contributes to egg-cell-dependent preferential fertilization in Arabidopsis” in the journal of Nature Plants, together with their colleagues from Wuhan Universities (groups of Prof. M.X. Sun & X. Xiong): https://www.nature.com/articles/s41477-023-01616-5. Congratulations to them.
Last year, our ICIPS PI, Prof. Sabine Zachgo (Univ. of Osnabrück) published a review paper about “Nuclear redox processes in land plant development and stress adaptation” in the journal Biological Chemistry (Degruyter Edition; Vol. 404, Issue 5). Congratulations!
2024

2023
We are proud to announce that our ICIPS member, Prof. Thomas Dresselhaus and his postdoctoral researcher, Xia Chen from the University of Regensburg published in the journal The Plant Cell an interesting paper on the role of RALF signalling pathway in the cell wall integrity during pollen tube growth in maize: https://academic.oup.com/plcell/article/36/5/1673/7492839.
Congratulations to them for this interesting work.
We are proud to announce that our ICIPS member, Melanie Trupp and Prof. Sabine Zachgo from the University of Osnabrück together with Oliver Rupp from JLU (Univ. of Gießen) published a very interesting “Marchantia” paper on the role of TGA transcription factors in the journal New Phytologist: https://nph.onlinelibrary.wiley.com/doi/10.1111/nph.19472. Congratulations to all these three ICIPS members.
Last month, seven ICIPS members (6 PhD-students & 1 Postdoc) took part to the second “Soft Skills” workshop about “Scientific Writing: How to present science and to publish in high impact factor journals” organized by ICIPS and provided by Dr. Michele Marass.
During this 2-day workshop, they learned together with 9 other JLU students about:
Part A: Publishing
– Writing a convincing cover letter,
– Finding the right journal,
– Understanding the publication process,
– What do Editors look for in a publication,
– What makes a great paper?
Part B: Scientific Writing
– How to draft your paper,
– The importance of the logical narrative,
– Dangers and opportunities of using AI to write paper,
– Formulating a compelling title,
– Structuring a well-balanced abstract,
Part C: Presenting Science
– Some basics of presentation,
– Making a poster,
– Some basics about figures & illustrations,
– Visual clarity and graph choice,
– Unethical research behaviour
On the last day, each student got his own paper abstract reviewed by Dr. Michele Marass (got comments & corrections) and learned a lot during an individual meeting how to improve his writing.
Thanks a lot to Dr. Michele Marass for this amazing workshop !!
Last month, seven ICIPS members participated to the Physcomitrium Lab-Training organized by Prof. Stefanie Müller-Schüssele (Univ. of Kaiserslautern) and her staff. During these 2 days, each participant learned to prepare some cultures of Physcomitrella patens and to screen them.
Thank you a lot to all the members of the working group P3 for helping and hosting this workshop.

Like, last year, our ICIPS PhD students and postdocs presented their new results to the whole research unit and we discussed them all together. This year, two external speakers, Dr. Beatrize Goncalves (Univ. of Bristol) & Prof. Ueli Grossniklaus (Univ. of Zürich) were invited to be part of the discussions.
Another difference compared to last year, two young PIs, Dr. Sophie de Vries (Univ. of Göttingen) & Dr. Anja Schmidt (Univ. of Heidelberg) were invited to present their researches in order to build future collaborations with ICIPS members. Thank a lot to all of them for their very constructive comments during the reteat.
Last month, all ICIPS members met in Regensburg for our second annual “Report & Retreat” Meeting!
We had intensive discussions and workshops during 3 days … and, of course, some well-deserved cold beers during the Regensburg Jazz festival on the evenings

Thomas Dresselhaus (UR, Regensburg) wrote a chapter about “Multiple roles of ROS in flowering plant reproduction” together with Liangzi Zhou in the newly published book “Oxidative Stress Responses in Plants” (Adv. Bot. Res. Vol. 108). Congratulations!
Annette Becker (JLU, Gießen) gave a talk about “Innovation and coevolution in land plant sexual reproduction, a case study in carpel evolution” during the session 6 focusing on “Evolution / Evo-Devo”, which took place during the third day morning of the MBP2023 Conference (Wednesday 8th of February) in Hennef (Germany).
Last week, Clemens Rössner (JLU, Gießen) presented a poster about his PhD project at the MBP2023 (Molecular Biology of Plants, section Plant Physiology and Molecular Biology of the German Botanical Society – Deutsche Botanische Gesellschaft DBG), which took place in Hennef near Bonn (Germany) from the 6th to the 9th of February. His poster (P-65) was titled: “The C1-1i type Zing Finger JAGGED from the EvoDevo point of view“. Annette Becker (JLU, Gießen) was his co-author.

Clemens Rössner posing in front of his poster
Picture: Dominik Lotz (JLU)
Last month, one of our ICIPS PhD student got her Christmas´ present a little earlier:
Melanie Trupp (from Zachgo´s group) received on the 14th of December the Award of the Best Master Thesis 2022 of the University of Osnabrück (UO), in the category “Organismic Biology“.
Master title: “Comparative analyses of NPR homologs in land plants”
Congratulations to her !
Here is the press release about it in UOS life journal (journal of the University of Osnabrück).

Picture: Lena Dehnen (UO)
Source: UOS life – Magazin & Blog des Fachbereichs Biology
2023

2022
International research teams, including one ICIPS member (Sabine Zachgo from Osnabrück University) published recently a review paper explaining why we should all work using Marchantia polymorpha!
They published it in The Plant Cell journal during October: https://academic.oup.com/plcell/article/34/10/3512/6670628
Citation:
J. Bowman et al. (2022), “The renaissance and enlightenment of Marchantia as a model system“; The Plant Cell 34 (10), 3512–3542.
DOI: 10.1093/plcell/koac219.
We are pleased to announce that the first Fiddlehead Forum (with thirteen scientific talks) took place online on Thursday 13th of Oktober at 4.30pm (German time) and included twenty-five c-fern lovers/participants from eleven working groups present in six different countries (Germany, UK, USA, Belgium, Netherlands, Mexico). A lot of interesting discussions were produced during this event!
The next one will be organised in six months !! Contact us (@Webmaster), if you want to be part of it!
Finally !!
All ICIPS members met in person in the framework of our annual Report & Retreat meeting in Villa Denis, near Kaiserslautern (except the working group of Günther Theißen at the FSU University, for Covid reasons) !

Stefanie Müller-Schüssele (TUK), Stefanie Sprunk (UR), Annette Becker (JLU), Thomas Dresselhaus (UR), Karina Brinkrolf (JLU), Sabine Zachgo (OU), Romain Scalone (JLU), Oliver Rupp (JLU).
from the left fo the right on the bottom line:
Clemens Rössner (JLU), Sophie Tiedemann (UR), Xia Chen (UR), Melanie Trupp (OU), Julian Ingelfinger (TUK), Julian Garrecht (JLU).
missing ICIPS members from the group picture:
Günther Theißen (FSU), Robin Schulz (FSU), Annalena Kurzweil (JLU).
Since 1st of October, Xia Chen joined the ICIPS research unit as postdoctoral researcher and she is going to work within the working group of Thomas Dresselhaus (P2) on Evolution of gametophytic communication. Welcome Xia !!
Last week, two German newspapers published an article regarding the results of the recent Nature Plants publication produced by our three ICIPS members:
– “Das genetische Geheimnis der widerstandsfähigen Farne” written by Hildegard Kaulen and published in the newspaper Frankfurter Allgemeine is including an interview of our ICIPS member : Günther Theissen (FKU, Jena) &
– „Warum Farne Gene horten“ published in the newspaper Gießener Anzeiger is also including interviews of our two ICIPS members: Annette Becker & Clemens Rössner (JLU, Gießen)!
Last week, two ICIPS members (Annette Becker & Stefanie Müller-Schüssele) presented the ICIPS research unit (FOR 5098) and their respective works to the 3rd Annual MadLand2022 Meeting in Herzogenhorn (within the Black Forest), near Freiburg.
Two days ago (on the 12th of September 2022), The New York Times newspaper published an article entitled „Cracking the Case of Giant Fern Genome“ written by Oliver Whang using the recent Nature Plants paper of our three ICIPS members as reference!
Justus-Liebig University published a press release entitled “Überlebenskünstler: Warum Farne Gene horten” about the publication produced by three of our ICIPS members (see previous News Info) published in Nature Plants about “Dynamic genome evolution in a model fern”.
This press release has been forwarded on the 6th of September by VBIO Verband Biologie, Biowissenschaften & Biomedizin in Deutschland.
International research teams, including three ICIPS members (Annette Becker, Clemens Rössner & Günther Theissen) sequenced and described the fern genome at chromosomal level !! They published their results on 1rst of September in Nature Plants : https://www.nature.com/articles/s41477-022-01226-7
Citation:
D. Blaine Marchant et al. (2022), “Dynamic genome evolution in a model fern”; Nature Plants 8, 1038-1051,
DOI: 10.1038/s41477-022-01226-7.
Last month, Julian Garrecht (JLU, Gießen) presented a poster about his PhD project at the Botanik-Tagung 2022 (International Conference of the German Society for Plant Sciences), which took place in Bonn (Germany) from the 28th of August to the 1st of September. His poster (P-298) was titled: “Using protoplasts transformation to assess the efficiency of multiple guideRNAs of a CRISPR/Cas system in planta“. Annette Becker (JLU, Gießen) was his co-author.

Four other ICIPS members (Annette Becker, Stephanie Müller-Schlüssele, Thomas Dresselhaus, Sabine Zachgo) were participating to this event by being co-authors of poster or oral presentations.
Sophie Tiedemann (UR, Regensburg) presented a poster about her PhD project at the 26th ICPSR Prague 2022 conference, which took place in Prague (Czech Republic) from the 20th to the 24th of June. His poster (P112) was titled: “Evolution and function of secreted small cysteine-rich EC1 proteins“. Stefanie Sprunck (UR, Regensburg) was one of her co-authors.
Last month, Robin Schulz (FSU, Jena) presented a poster about his PhD project at the EURO EVO DEVO 2022 conference, which took place in Napoli (Italy) from the 30th of Mai to the 3rd of June. His poster (P007) was titled: “Establishing the fern Ceratopteris as a model system to investigate the evolutionary origin of the seed“. Prof. Günther Theissen (FSU, Jena) was one of his co-authors.

Two other ICIPS members participated to this event in Napoli : Sabine Zachgo (OU, Osnabrück) gave a talk about “How stressful was plant terrestrialization? Contribution of transcription factors and redox processes in land plant adaptation” during the session N°12 focusing on “Conquering Land: the first steps of plants and animals towards terrestrialization” chaired by Annette Becker (JLU, Giessen) on Thursday morning 2nd of June.
Sophie Tiedemann started her PhD degree this month (Mai 2022) at the University of Regensburg. She will be supervised by Stefanie Sprunck and her DFG project is titled: “Evolutionary history of ECA1 gametogenesis-related proteins and their roles in seed plant reproduction“.
Thomas Dresselhaus seeks two highly motivated postdoctoral researchers (m/f/d) to work in the field of maize reproductive biology. The positions (100% TV-L E13 salary – 4 years each) could be extended and offer the possibility to further qualify as independent principal investigator. Both positions are available immediately. The Position #2 is part of the DFG Research Unit ICIPS (Innovation and Coevolution in Plant Sexual Reproduction) and shall study the evolution of gametophytic communication systems by analyzing RALF and ROS signaling using maize and Physcomitrium as model systems.
Melanie Trupp started her PhD degree this month (March 2022) at the University of Osnabrück. She will be supervised by Sabine Zachgo and her DFG project is titled: “Contribution of the TGA/NPR network and redox regulation to the evolution of sexual reproduction“.
Robin Schulz started his PhD degre last month (December 2021) at the Friedrich Schiller University in Jena. He will be supervised by Günther Theißen and his DFG project is titled: “On the Origin of the seed habit“.
2022

2021

Another Julian, Julian Ingelfinger, started his PhD degree in December at the Technical University of Kaiserslautern. He will be supervised by Stefanie Müller-Schüssele and his DFG project is titled: “ROS bursts in plant growth and fertility: Evolution and diversification of the NADPH oxidase family“.
The first Introduction/Kickoff Meeting of the ICIPS research unit (FOR 5098) took place online (due to Covid regulations) on Tuesday 14th of December from 14:30 to 18:00.
All PIs were present and introduced themselves and their new ICIPS members (e.g., PhD students, postdocs and/or technical assistants) to the whole research unit.
Julian Garrecht started his PhD degree in November at the Justus Liebig University in Giessen. He will be supervised by Annette Becker and his DFG project is titled: “400 million years of faith – how the transcriptional regulators LUG and SEU co-evolved to become key regulators of reproductive development in A. thaliana“.
Romain Scalone will be the new scientific coordinator of the whole ICIPS research unit – FOR 5098 – and started his work in November. He is located within the Becker Group at the Justus Liebig University in Giessen.
Happy to announce that our new DFG funded research unit:
ICIPS (for Innovation and Coevolution In Plant Sexual reproduction) is ready to get started !
2021
